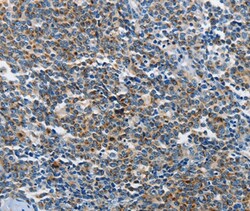
Invitrogen NEK1 Polyclonal Antibody 100 &mu;L; Unconjugated:Antibodies,

missing translation for 'onlineSavingsMsg'
Learn More
Learn More
Invitrogen™ NEK1 Polyclonal Antibody


Rabbit Polyclonal Antibody
Brand: Invitrogen™ PA550614
This item is not returnable.
View return policy
Description
The antibody detects endogenous levels of total NEK1 protein.
NEK1 is a serine/threonine protein kinase, related to the NIMA cell cycle regulator, and is highly expressed in meiotic germ cells. The kinase may function early in the DNA damage response pathway. NEK1 may also participate in polycystic kidney disease and neural cell development. Like most members, the encoded protein contains an N-terminal pleckstrin homology domain and a highly conserved C-terminal OSBP-like sterol-binding domain.
Specifications
| NEK1 | |
| Polyclonal | |
| Unconjugated | |
| NEK1 | |
| D8Ertd790e; DKFZp686D06121; DKFZp686K12169; kat; KIAA1901; kidney, anemia and testis; MGC138800; NEK1; Nek1 serine/threonine- and tyrosine-specific protein kinase; never in mitosis A-related kinase 1; NIMA (never in mitosis gene a)-related expressed kinase 1; NIMA (never in mitosis gene a)-related kinase 1; NIMA related kinase 1; NIMA-related kinase 1; nimA-related protein kinase 1; NY\ REN55; NY-REN-55; NY-REN-55 antigen; protein-serine/threonine kinase; renal carcinoma antigen NY-REN-55; Serine/threonine-protein kinase Nek1; SRPS2; SRPS2A; SRTD6 | |
| Rabbit | |
| Antigen affinity chromatography | |
| RUO | |
| 18004, 4750 | |
| -20°C | |
| Liquid |
| Immunohistochemistry (Paraffin) | |
| 1 mg/mL | |
| PBS with 40% glycerol and 0.05% sodium azide; pH 7.4 | |
| P51954, Q96PY6 | |
| NEK1 | |
| Synthetic peptide corresponding to a region derived from internal residues of human NIMA-related kinase 1. | |
| 100 μL | |
| Primary | |
| Human, Mouse | |
| Antibody | |
| IgG |
Product Content Correction
Your input is important to us. Please complete this form to provide feedback related to the content on this product.
Product Title
Spot an opportunity for improvement?Share a Content Correction